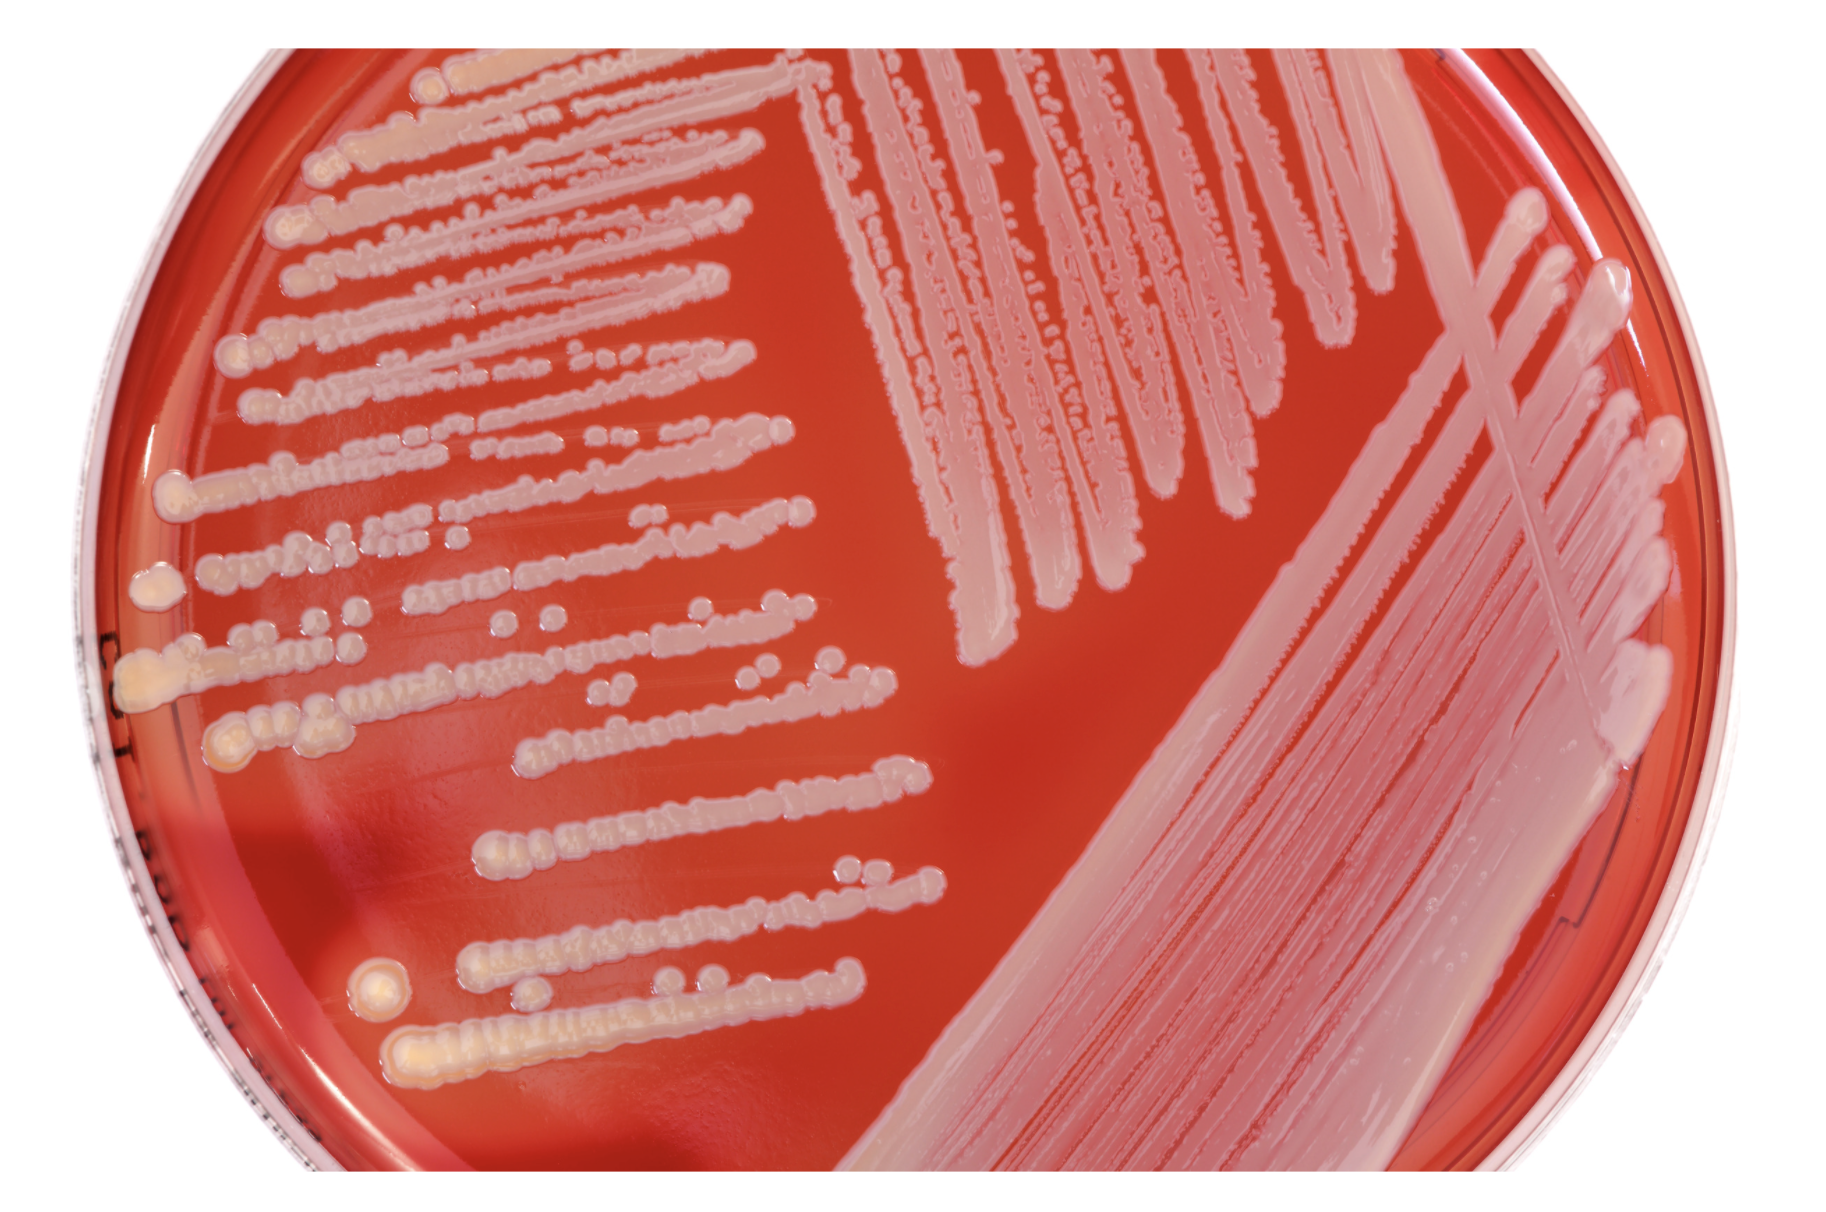

Кровяной мпа
Синьор это выход
Что такое выносливость определение
Olive juice
Как поставить тайм код
А что такое подробней
Асу fg
Эксфорж таблетки от давления инструкция
Амортизатор кабины даф задний
7 499 653 75 03
Включи таймер не таймер
Структура технологического процесса обработки детали
Я всегда буду с тобой минусовка
Чему равна погрешность мензурки на рисунке
Кровяной мпа 138 фото